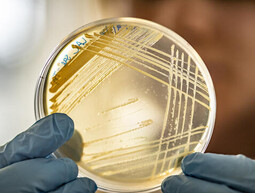

Browse A-Z Subjects
Images categorised by subject.
Subcategories of A-Z Subjects
List of access levels
Archaeology
folder, containing
35
items
Arts
folder, containing
2
items
Biological Sciences
folder, containing
2
items
Business & Management
folder, containing
13
items
Chemistry
folder, containing
9
items
Geography
folder, containing
1
items
History
folder, containing
8
items
Medical
folder, containing
38
items
Nursing & Midwifery
folder, containing
14
items
Physics
folder, containing
8
items
Politics
folder, containing
1
items
Science
folder, containing
41
items
Teacher Training
folder, containing
6
items
Looks like those filters don't match any items
Try a more generic search term, or clear any filters you may have.
Your search did not match any items
Try a more generic search term, or clear any filters you may have.
We've used some of the latest web technologies that your browser does not support. Some functionality might not work as expected. Try upgrading to one of our recommended browsers .
 Archaeology folder, containing 35 items
Archaeology folder, containing 35 items Arts folder, containing 2 items
Arts folder, containing 2 items Biological Sciences folder, containing 2 items
Biological Sciences folder, containing 2 items Business & Management folder, containing 13 items
Business & Management folder, containing 13 items Chemistry folder, containing 9 items
Chemistry folder, containing 9 items Geography folder, containing 1 items
Geography folder, containing 1 items History folder, containing 8 items
History folder, containing 8 items Medical folder, containing 38 items
Medical folder, containing 38 items Nursing & Midwifery folder, containing 14 items
Nursing & Midwifery folder, containing 14 items Physics folder, containing 8 items
Physics folder, containing 8 items Politics folder, containing 1 items
Politics folder, containing 1 items Science folder, containing 41 items
Science folder, containing 41 items Teacher Training folder, containing 6 items
Teacher Training folder, containing 6 items